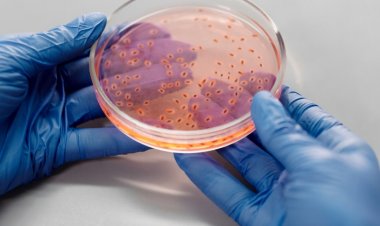
Maymun Çiçeği Virüsü Nasıl Bulaşır? Belirtileri Nelerdir?

Portalımız daha iyi bir deneyim için çerez kullanmaktadır. Portalımızda ziyaretinize devam etmeniz durumunda çerez politikamızı kabul etmiş sayılırsınız.
Etiket: maymun çiçeği
Bilim İnsanları Maymun Çiçeğinin Adının Değiştirilmesini...
Önde gelen uluslararası bir araştırmacı grubu, maymun çiçeği isminin değiştirilmesini önerdi. Batı Afrika, Kongo suşları için yapılan adlandırmanın coğrafi...
Maymun Çiçeği Hakkında Doğru Bilinen Yanlışlara Dikkat!
Maymun çiçeği virüsü nedir ve maymun çiçeği virüsü hakkında doğru bildiğimiz yanlışlar nelerdir? Medline uzmanlarından Dr. Ferit Şeyhzade virüsle ilgili...
Şüpheli Maymun Çiçeği Vakalarının Test Sonuçları Belli...
Sağlık Bakanı Fahrettin Koca, İstanbul'da maymun çiçeği şüphesi bulunanların test sonuçlarının negatif çıktığını açıkladı.
İstanbul'da Maymun Çiçeği Endişesi: 3 Kişi Gözlem Altında
İstanbul Sultangazi'de yabancı uyruklu 2 kişi ellerinde çıkan yaralar nedeniyle eczaneye giderek ilaç istedi. Maymun çiçeğinden şüphelenen eczacı, polis...
Uzmanlardan 'Maymun Çiçeği Hayvanlara Yayılabilir' Uyarısı
Dünyada hızla yayılan maymun çiçeği virüsü hayvanları da tehdit ediyor.
Pfizer’den Maymun Çiçeği Açıklaması
Pfizer’ın CEO’su Bourla maymun çiçeği virüsüyle ilgili mevcut verilerin Covid-19 gibi diğer virüsler kadar kolay bulaşmadığını ve bir pandemiye yol açmasının...
Maymun Çiçeği Nasıl Bulaşır? Virüsten Korunmanın Yolları...
Avrupa ülkeleri ve ABD’nin de aralarında olduğu bir çok ülkede ortaya çıkan Maymun Çiçeği hastalığının belirtileri neler? Maymun Çiçeği virüsünden nasıl...
15 Soru-15 Cevap ile KLİMİK'ten Maymun Çiçeği Hastalığı
KLİMİK Derneği, dünyada hızla yayılan Maymun Çiçeği hastalığı hakkında en çok merak edilen 15 soruyu yanıtladı.
Maymun Çiçeği Virüsü Nasıl Bulaşır? Belirtileri Nelerdir?
Başta İngiltere olmak üzere birçok ülkede hızla yayılan maymun çiçeği virüsü nedir, belirtileri nelerdir? İşte detaylar...
DSÖ Uyardı: Maymun Çiçeği Virüsü Avrupa'da Yayılabilir!
Dünya Sağlık Örgütü, maymun çiçeği virüsünün dünyada yayılmasının üzerine acil toplanma kararı aldı. Örgüt yaz aylarında virüsün Avrupa’da yayılmasının...